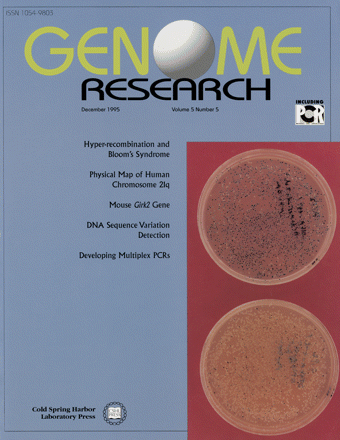
Cover image expansion

COVER In vivo detection of DNA sequencing variation. Transformation plates of the mismatch at position -49 of the mouse ß-globin promoter. (Top) T/T, no mismatch, blues colonies; (bottom) T/C, mismatch with many colonies. (For details, see Faham and Cox, p. 474.)